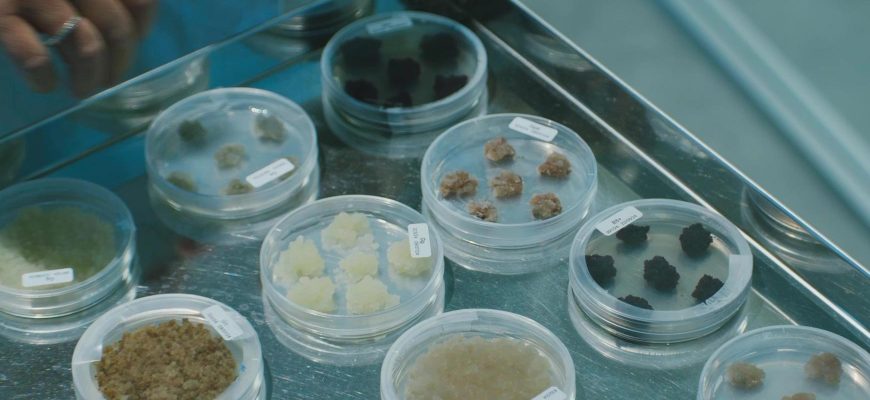

The excellence of Italian biotechnology becomes a key partner of MyCli in the development of Liftable Overnight Cream, through an active ingredient that has shown outstanding performance in optimizing the quality of dermal collagen and elastin.
Created in the Italian laboratory Aethera Biotech, led by Dr. Giovanna Pressi, the enhanced meristematic cell complex—LOXstem—was developed through a patented method, strictly protected by industrial secrecy. Walking through the labs where this active is derived from just a few mother cells of a plant meristem is a unique and inspiring experience, one that fills us with pride in the professional quality of our scientists and the entrepreneurial strength of Italy.
Starting from the mother cells of Zanthoxylum Piperitum, after 30 days of cultivation in environments enriched with minerals and micronutrients, an ingredient enhanced with lignans is obtained. This ingredient improves both the quality and quantity of dermal fibers by regulating the enzymes that break them down or activate them.
The process takes place in sterile environments using equipment created by Aethera Biotech to maximize each plant’s potential, in collaboration with university research centers that scientifically validate the molecule’s action.
In vitro tests show a 70% increase in pro-collagen levels* compared to control, and a reduction in collagen-degrading enzymes, bringing collagenase concentration down to 0.5% and elastase to 2%. In vivo testing showed a 78% increase in skin elasticity after 4 to 6 weeks of treatment compared to baseline (T0)**.
The inclusion of this ingredient positions MyCli’s Research & Development at the forefront of innovation, offering proven efficacy in addressing one of the most important skincare concerns: preserving tone and firmness.
*In vitro test on fibroblast cultures evaluating pro-collagen I synthesis: 70% increase compared to control. Stimulation with methylprednisone alters pro-collagen expression. LiftyLOX counteracts this alteration at concentrations of 0.002%, 0.02%, and 0.2%.
**In vivo test using a cream containing 2% LiftyLOX applied morning and evening to the neck and décolleté. Visia Complex Analyzer: 78% increase in elasticity after 4 and 6 weeks compared to T0. 100% of participants showed this improvement.